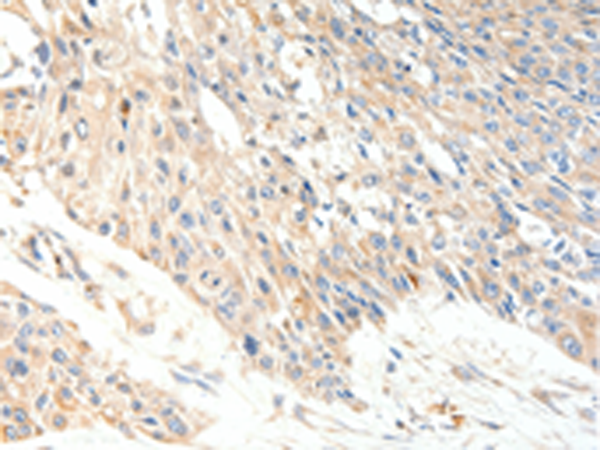

|
Background: |
The protein involved in translocation of long-chain fatty acids (LFCA) across the plasma membrane. The LFCA import appears to be hormone-regulated in a tissue-specific manner. In adipocytes, but not myocytes, insulin induces a rapid translocation of FATP1 from intracellular compartments to the plasma membrane, paralleled by increased LFCA uptake. Plays a pivotal role in regulating available LFCA substrates from exogenous sources in tissues undergoing high levels of beta-oxidation or triglyceride synthesis. May be involved in regulation of cholesterol metabolism. Has acyl-CoA ligase activity for long-chain and very-long-chain fatty acids .Highest levels of expression are detected in muscle and adipose tissue small, intermediate levels in small intestine, and barely detectable in liver. |
|
Applications: |
ELISA, IHC |
|
Name of antibody: |
SLC27A1 |
|
Immunogen: |
Synthetic peptide of human SLC27A1 |
|
Full name: |
solute carrier family 27 (fatty acid transporter), member 1 |
|
Synonyms: |
FATP; FATP1; ACSVL5 |
|
SwissProt: |
Q6PCB7 |
|
ELISA Recommended dilution: |
2000-5000 |
|
IHC positive control: |
Human esophagus cancer and Human lung cancer |
|
IHC Recommend dilution: |
50-200 |
購物車
購物車 幫助
幫助
 021-54845833/15800441009
021-54845833/15800441009
